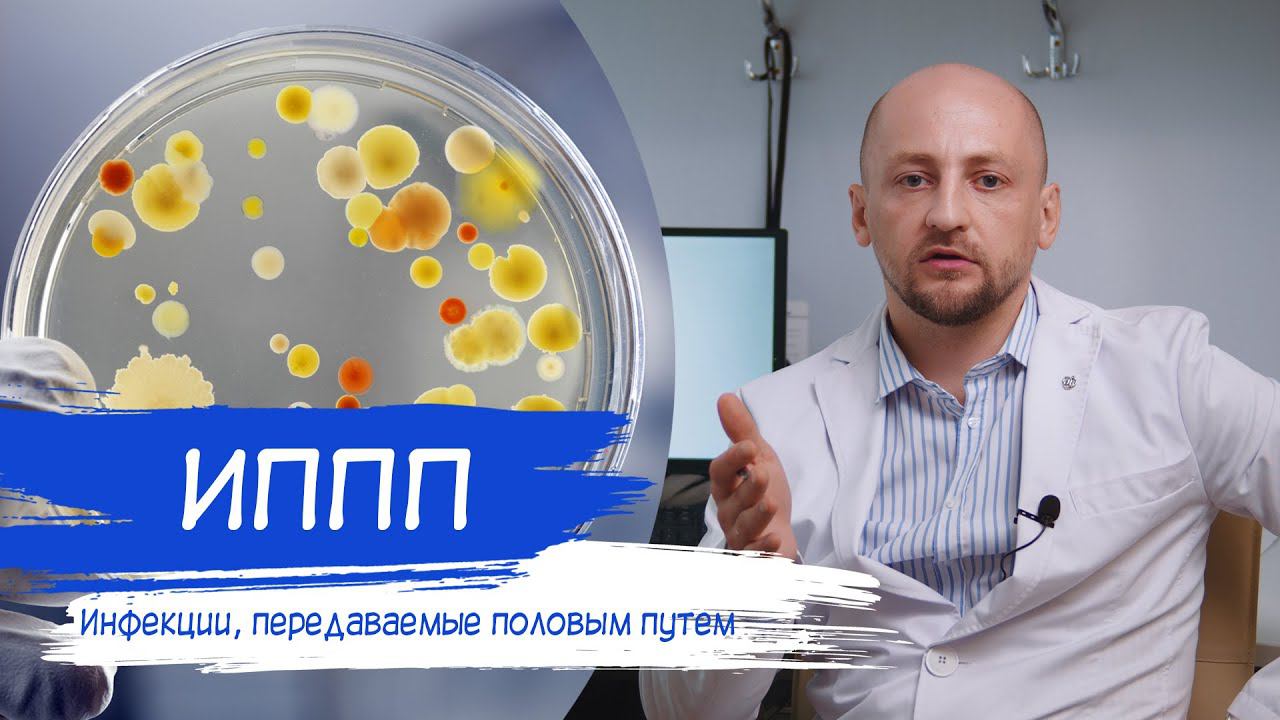
Инфекции передаваемые половым путем | ИППП смотреть онлайн

Автор: МЕДБЛОГ Страница 2

УДЛИНЕНИЕ ИНТЕРВАЛА QT | В чем причина удлиненного QT?

ВНУТРИСУСТАВНЫЕ ИНЪЕКЦИИ _ Блокада, PRP-терапия, Гиалуроновая кислота

Повреждения мениска, Разрыв связки, Вывих плечевого сустава | ОТВЕТЫ НА ВАШИ ВОПРОСЫ

ВАРИКОЗ ОПЕРАЦИЯ | Лазер или Скальпель?

ВАРИКОЗ | Лечение варикоза

Искривление носовой перегородки #септопластика #нос #искривлениеносовойперегородки

СЕПТОПЛАСТИКА | Искривление носовой перегородки

ПУПОЧНАЯ ГРЫЖА | Симптомы и лечение

ОБМОРОК | Причина потери сознания

УШНУЮ СЕРУ НЕЛЬЗЯ УБИРАТЬ #ушнаясера #чисткаушей #отит #ушныепалочки

ОТКРЫТОЕ ОВАЛЬНОЕ ОКНО | Норма или патология?

КАК НЕ ИСПОРТИТЬ ВЕНЫ ПРИ ХИМИОТЕРАПИИ? | ПОРТ-СИСТЕМА

ПОДГОТОВКА К ОПЕРАЦИИ НА СУСТАВАХ | Преабилитация

Лыжи или Сноуборд ЧТО ОПАСНЕЕ? Травмы при катании на лыжах и сноуборде

УДЛИНЕНИЕ ИНТЕРВАЛА QT | В чем причина удлиненного QT?

ВСД Вегетососудистая дистония | Ваготония

ПРИВЫЧНЫЙ ВЫВИХ ПЛЕЧЕВОГО СУСТАВА | Рецидивирующий вывих плеча

ВЫВИХ ПЛЕЧА | Повреждения плечевого сустава

ГАЙМОРИТ ПОСЛЕ ГРИППА | Как лечить ГАЙМОРИТ

ПЕРЕВЯЗКА ПОСЛЕ ОБРЕЗАНИЯ | Как делать?
Инфекции передаваемые половым путем | ИППП

ФИМОЗ | Обрезание крайней плоти

ПОЛИПЫ, ПАНКРЕАТИТ, ХОЛЕЦИСТИТ | ПРЕДРАК ЖКТ

ТРАНСПЛАНТАТЫ СВЯЗОК КОЛЕННОГО СУСТАВА
За каждым успешным каналом стоит личность, идея и сотни часов кропотливого труда. Если вы здесь, значит, автор «МЕДБЛОГ» уже сумел зацепить ваше внимание своим уникальным стилем или подачей. А мы на RUVIDEO позаботились о том, чтобы вы могли изучить весь архив его работ в максимально комфортных условиях — без лишней суеты и преград.
Почему за работами канала «МЕДБЛОГ» так интересно наблюдать? Всё просто: это честный контент, который находит отклик в сердцах зрителей. На нашем ресурсе вы можете смотреть онлайн все видео любимого автора бесплатно и в хорошем качестве. Нам важно, чтобы вы видели каждую деталь и слышали каждый нюанс, поэтому мы используем только стабильные плееры из открытых источников Rutube.
Следите за новинками канала, пересматривайте старые шедевры и открывайте для себя новые грани творчества «МЕДБЛОГ». Мы постоянно обновляем ленту, чтобы у вас под рукой всегда были самые свежие выпуски. Никаких сложных регистраций — только вы и творчество, которое вдохновляет. Приятного вам путешествия по миру авторского контента на RUVIDEO!
Видео взято из открытых источников Rutube. Если вы правообладатель, обратитесь к первоисточнику.